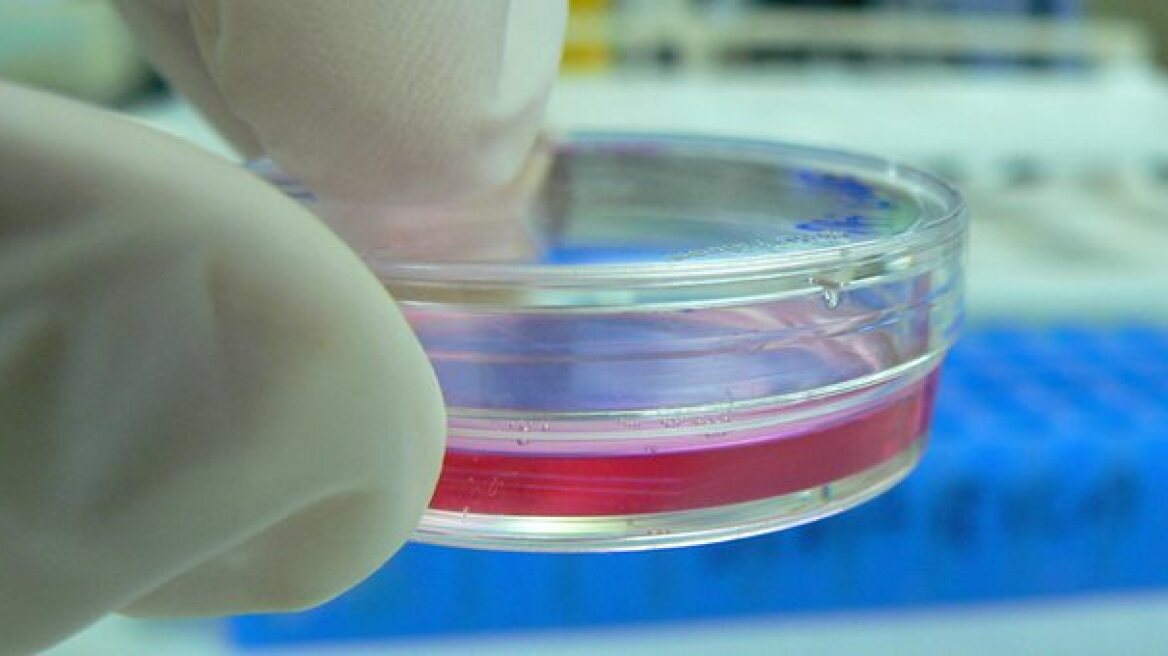
Δύο νέα φάρμακα στη «μάχη» κατά του καρκίνου του προστάτη

Δύο νέα φάρμακα από το στόμα ανατρέπουν τα δεδομένα στη θεραπεία του προχωρημένου καρκίνου του προστάτη. Πρόκειται για την οξική αμπιρατερόνη, που χρησιμοποιείται ευρέως πια και στη χώρα μας και την ενζαλουταμίδη, που σύντομα θα είναι διαθέσιμη στην ελληνική αγορά.
«Οι δύο αυτές νέες θεραπείες δίνουν ελπίδες στους ασθενείς για αύξηση της επιβίωσης και δεν αποκλείεται αργότερα να λάβουν έγκριση και για πιο αρχικούς προστατικούς καρκίνους, ώστε να αντικαταστήσουν εν μέρει την κλασική χημειοθεραπεία» εκτιμά ο πρόεδρος του Ινστιτούτου Μελέτης Ουρολογικών Παθήσεων (ΙΜΟΠ) και καθηγητής Ουρολογίας στο ΑΠΘ Δημήτρης Χατζηχρήστου.
«Ο καρκίνος του προστάτη αποτελεί τον πιο συχνό καρκίνο στους άντρες και τη δεύτερη συνηθέστερη αιτία θανάτου από καρκίνο. Ένας στους έξι άντρες θα αναπτύξει καρκίνο του προστάτη, ενώ εκείνοι που ο πατέρας ή ο αδελφός τους (πρώτου βαθμού συγγένεια) έχει προσβληθεί από τον καρκίνο έχουν διπλάσιες πιθανότητες» επισημαίνει ο κ. Χατζηχρήστου, με αφορμή την 15η Σεπτεμβρίου, που έχει καθιερωθεί ως Ευρωπαϊκή Ημέρα κατά του Καρκίνου του Προστάτη.
Παράλληλα, τονίζει τη σημασία της έγκαιρης διάγνωσης, η οποία είναι απλή και εφικτή, αρκεί κάθε άντρας 50 ετών να έχει ευαισθητοποιηθεί και να έχει ενημερωθεί σχετικά.
«Για πολλά χρόνια, η αξιολόγηση του ειδικού προστατικού αντιγόνου ήταν λάθος, αφού τιμές PSA πάνω από 4 ήταν ένδειξη καρκίνου. Γιατί το PSA απλώς δεν έχει φυσιολογικές τιμές. Κατ' αρχάς, αυξάνεται σε όλες τις παθήσεις του προστάτη, συνεπώς και στην προστατίτιδα και στην καλοήθη υπερτροφία του προστάτη. Μάλιστα, η ετήσια αύξηση, μετά την ηλικία των 50 ετών, μπορεί να είναι 0,25, επειδή μεγαλώνει ο προστατικός αδένας. Ένα άλλο θέμα είναι ότι το PSA μπορεί να αυξηθεί πολύ σε μικρό χρονικό διάστημα (λ.χ. από 3 σε 7 μέσα σε λίγες μέρες) εξαιτίας φλεγμονής του προστάτη, δηλαδή προστατίτιδας. Στην οξεία προστατίτιδα, μπορεί να φθάσει και σε τιμές 50 ή και πάνω από 100. Στον καρκίνο, όμως, η αύξηση του PSA είναι μικρή και σταθερή- μπορεί, λ.χ., από 3 να γίνει 4 σε διάστημα τριών μηνών και στο εξάμηνο να έχει φτάσει στο 6 έως 8. Επειδή λοιπόν το PSA έχει διάφορα μοντέλα αυξομειώσεως, οι ειδικοί μιλούν πλέον για τιμές αναφοράς. Ένα PSA, που μέσα σε έναν χρόνο αυξάνεται σταδιακά από το 1 στο 3, μας δίνει υπόνοιες καρκίνου, αλλά αν παραμένει κάτω από 10, υποδηλώνει τοπική νόσο χωρίς μεταστάσεις. Αν, όμως, δούμε σε κάποιον ασθενή τιμές αυξανόμενες στο PSA -και συνήθως πάνω από 20- τότε το πιθανότερο είναι να υπάρχουν μεταστάσεις στα οστά. Τέλος, μόνο το PSA δεν αρκεί για να ελεγχθεί η υγεία του προστάτη. Πρέπει πάντοτε η μέτρησή του να συνοδεύεται από δακτυλική εξέταση του προστάτη από ουρολόγο» εξηγεί ο κ. Χατζηχρήστου.
Οι θεραπείες
Στη θεραπεία του καρκίνου του προστάτη έχουν γίνει μεγάλα βήματα προόδου, αφού έχει εξελιχθεί η χειρουργική αντιμετώπιση, ενώ έχει αλλάξει ριζικά μορφή η αντιμετώπιση του προχωρημένου μεταστατικού καρκίνου με τα νέα φάρμακα που αντικαθιστούν τη χημειοθεραπεία και αντιμετωπίζουν τη σημαντικότερη μεταστατική εστία της νόσου, τις μεταστάσεις στα οστά.
Η επιθετικότητα του καρκίνου εξαρτάται από την εντόπισή του (σε ένα σημείο ή πολλά), την έκτασή του και τη βαθμολογία κατά Gleason. Το γνωστό και ως Gleason score είναι ένα σύστημα 10 βαθμίδων που δείχνει πόσο έχουν χάσει τη δομή τους τα κύτταρα του προστάτη. Όσο πιο επιθετικός είναι ο καρκίνος, τόσο πιο ασχημάτιστα (αδιαφοροποίητα) είναι τα κύτταρα και τόσο μεγαλύτερο το score.
«Τιμές στο Gleason score μέχρι 4 υποδηλώνουν καρκίνο σε πρώιμο στάδιο, γεγονός που στις μεγάλες ηλικίες (πάνω από 70 έτη) συνήθως χρειάζεται μόνο παρακολούθηση, διότι ξέρουμε ότι ο καρκίνος του προστάτη σε αυτή τη μορφή και ηλικία εξελίσσεται πολύ αργά. Τιμές στο Gleason score 5 έως 7 σημαίνουν καρκίνο, ο οποίος πρέπει να αντιμετωπιστεί με ολική αφαίρεση του προστάτη (ριζική προστατεκτομή) ή ακτινοβολία (εξωτερική ή με εμφύτευση ειδικών ακτινοβολούντων 'σπόρων', τη λεγόμενη βραχυθεραπεία), ενώ Gleason score από 8 έως 10 υποδηλώνει έναν ιδιαίτερα επιθετικό καρκίνο, ο οποίος -εάν δεν είναι ήδη μεταστατικός- πιθανότατα θα εξελιχθεί στους επόμενους μήνες» εξηγεί ο κ. Χατζηχρήστου.
Η κλασική θεραπεία του προχωρημένου καρκίνου του προστάτη είναι η ορμονοθεραπεία. Βασίζεται στη χορήγηση (με ένεση) μία φορά το μήνα ή το τρίμηνο μιας ορμόνης, η οποία μπλοκάρει την τεστοστερόνη- την ανδρική ορμόνη που είναι απαραίτητη για την εξέλιξη του καρκίνου του προστάτη. Πολλοί ασθενείς θα ζήσουν πολλά χρόνια με τη θεραπεία αυτή, η οποία ακόμη και στο μεταστατικό καρκίνο δίνει άριστα αποτελέσματα, τα πρώτα περίπου 2-5 χρόνια με πλήρη αναστροφή των μεταστάσεων.
Ωστόσο, η ορμονοθεραπεία οδηγεί πολύ γρήγορα σε βαριά οστεοπόρωση και το 20% των ανδρών αυτών θα υποστούν κάποιο κάταγμα. Πρόσφατα κυκλοφόρησε ένα μονοκλωνικό αντίσωμα, η δενοσουμάμπη, με επιλεκτική δράση κατά των μηχανισμών οστικής καταστροφής, που μειώνει τα κατάγματα σπονδύλων. Η ίδια θεραπεία, σε μεγαλύτερη δόση, χορηγείται και στους ασθενείς με οστικές μεταστάσεις, ώστε να μην υποστούν αυτόματα κατάγματα.
Όταν οι ασθενείς παύουν να ανταποκρίνονται στην ορμονική θεραπεία, το επόμενο θεραπευτικό βήμα είναι η χημειοθεραπεία. Η πρώτη γραμμή χημειοθεραπείας είναι το φάρμακο δοσεταξέλη και η καμπαζιταξέλη. Πρόσφατα, δύο νέα που λαμβάνονται από το στόμα, η οξική αμπιρατερόνη και η ενζαλουταμίδη ανέτρεψαν τα δεδομένα στη θεραπεία του προχωρημένου καρκίνου του προστάτη δίνοντας ελπίδες για την αύξηση της επιβίωσης.
Σεξουαλική δραστηριότητα και νεοπλασία προστάτη
Η αντιμετώπιση του καρκίνου του προστάτη αποτέλεσε ένα από τα αντικείμενα του 1ου Ελληνοτουρκικού Συνεδρίου, που διοργάνωσε η Ουρολογική Εταιρεία Βορείου Ελλάδος.
Στη διάρκεια του συνεδρίου, Έλληνες και Τούρκοι ουρολόγοι αντάλλαξαν εμπειρίες από την παρακολούθηση των αρχικών σταδίων του προστάτη ή των ύποπτων περιστατικών, αλλά και απόψεις σχετικά με τον καθορισμό αλγορίθμων διάγνωσης και θεραπείας στα περιστατικά υψηλού βαθμού επικινδυνότητας. Καθόρισαν, επίσης, τις παραμέτρους για την αντιμετώπιση, με τον καλύτερο επιστημονικά και λιγότερο επιθετικό τρόπο, διασφαλίζοντας την αρτιότητα του ασθενούς, από κάθε άποψη, χωρίς τον κίνδυνο επέκτασης.
«Η θεραπεία του καρκίνου του προστάτη είτε χειρουργικά ή με ακτινοβολίες είτε φαρμακευτικά μειώνει τη σεξουαλική δραστηριότητα του ασθενούς. Στα περιστατικά που είναι ύποπτα για νεοπλασία περιμένουμε να έχουμε ενδείξεις ότι θα αναπτυχθεί καρκίνος πριν προχωρήσουμε στη θεραπεία ώστε να διατηρήσουμε τη σεξουαλική δραστηριότητα του ασθενούς μέχρι να έρθει η ώρα» ανέφερε στο ΑΠΕ-ΜΠΕ ο πρόεδρος της Ουρολογικής Εταιρείας Βορείου Ελλάδος Χάρης Αηδονόπουλος.